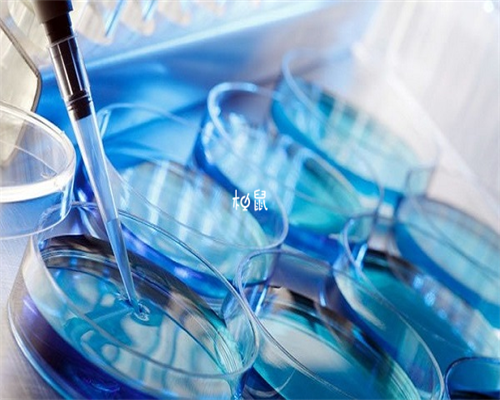
上海助孕宝宝多久会走路

上海助孕宝宝多久会走路......
来源:未知 阅读量:437时间:2024-05-04
宝宝一般在1岁左右学会走路。生长发育健康的宝宝在11月龄时就可以慢慢站立,尝试走路了,刚开始学习走路时,因宝宝下肢力量不够,需要家长搀扶,尽量不要站立太长时间,循序渐进,期间家长需要耐心引导,在1岁左右,宝宝一般就可以完成独立走路。
最新文章
友情链接:

Copyright © 2002-2030 沪ICP备2024069976号-1 上海必为投资管理有限公司 上海市闵行区元江路5500号第1幢6024室上海试管中心版权所有